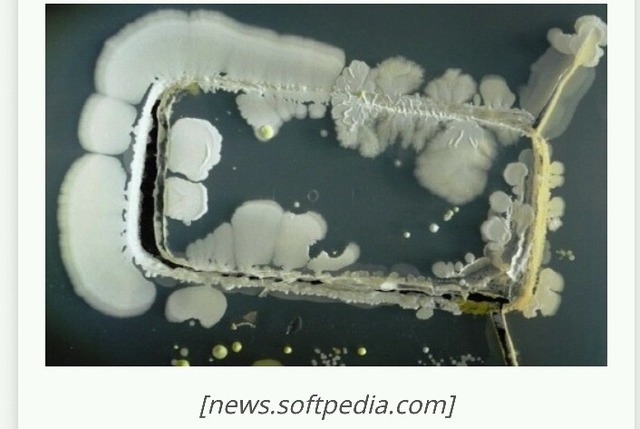

213 읽음
알아봐야 좋을것 없는 짜증나는 정보들. TMI
여드름 진드기는 따뜻하며 기름진곳을 좋아해, 모낭에 기생한다. 이 진드기는 거의 모든 성인의 두피,눈썹,그리고 '유두'에 기생 하고 있다.
2.
어른 한 사람이 한번에 누는 대변의 양은 약 113g이며, 그 절반은 장 속 박테리아의 "시체"로 구성되어 있음.
3.
장까지 닿는 유산균 요구르트의 유산균은
'똥에서 채집한 유산균'을 배양한 것.
4.
비행기에 설치된 산소마스크,
탱크 용량에 한계가 있어 15분정도만 산소가 공급됨.
5.
하늘에서 번개가 칠 때
번번이 날고있는 비행기로 내리꽂히는 경우가 많음. (...그런다고 비행기가 추락하진 않지만... )
6.
목도리는 단 일주일만에
집먼지진드기로 가득 가득 차게 된다.
사진 처럼

공중화장실 변기 박테리아 1제곱미터당 160마리.
스마트폰 표면엔 그 '10배'의 박테리아가 살고있음.
샴푸 다쓰고 같은 통에 리필해서 사용하면
세균(녹농균)으로 머리 감는거랑 똑같다.
9.
페트병을 열었으면 재빨리 다 마셔버리자
단 하루만에 그 안에 몇십억마리 세균이 번식한다.
10.
양수의 대부분이 태아의 소변임
우린 그(오줌) 안에서 싸고 헤엄치고 마시며 열달을 살아감.
11.
모기는 피를 빨때 6개의 바늘을
우리 몸에 박아서 효율적으로 흡혈

초콜릿바에는 평균 8개의 벌레다리가 들어있다.
카카오는 고온다습한 환경에서 잘 자란다.
필요한 하루 일조량이 평균 5시간이나 되는 햇빛이 많이 필요한 열매임에도 불구하고,
비료가 적게 들고 습한 환경 유지에 유리한 그늘재배 방식을 사용한다.
벌레가 꼬이기 참 좋은 환경. 재배된 카카오에는 항상 벌레가 그득그득 하다.

와 다 필요가 한 개도 없음 ;;